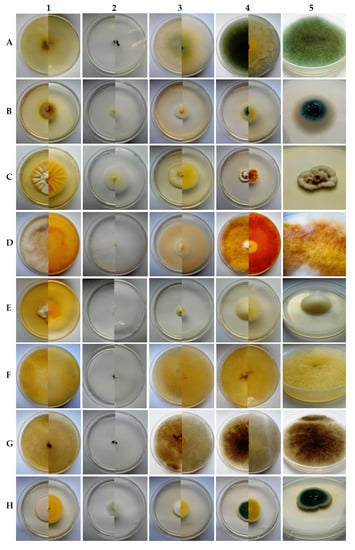
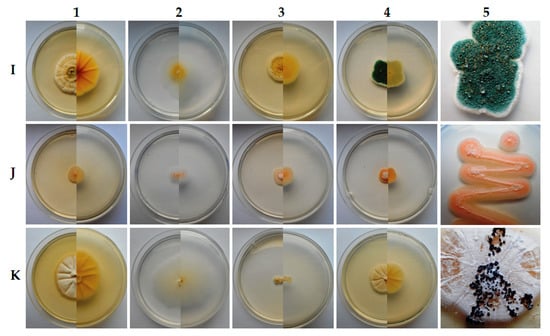

Abstract
Underground ecosystems are one of the most inhospitable places for microorganism development and function. Therefore, any organic matter located in these areas can stimulate fungal growth. The main purpose of this study was to find the best solution to effectively preserve (without relapses) paleolithic bones of cave bear (Ursus spelaeus) exhibited in cave without any negative influence on the cave environment. To achieve this aim, unambiguous identification of fungal species and its susceptibility tests toward fungicidal preparations were performed. Fungi were identified based on phenotypic tests and the internal transcribed spacer (ITS) region analysis. The antifungal activity of three preparations (Pufmax, Boramon and Devor Mousse) was evaluated by microdilution assay (protocol M38-A2) and spot tests assay. Phenotypic and molecular research showed that bones were colonized by 11 fungal species: Absidia glauca, Aspergillus fumigatus, Chrysosporium merdarium, Fusarium cerealis, Mortierella alpina, Mucor aligarensis, M. plumbeus, Penicillium chrysogenum, P. expansum, Sarocladium strictum and Scopulariopsis candida. All of the tested preparations were the most active against C. merdarium. In turn, M. plumbeus, M. aligarensis, M. alpina and A. glauca were the least susceptible. The highest antifungal activity was shown for Pufmax (minimum inhibitory concentration (MIC) and minimal fungicidal concentration (MFC) values were in the range of 0.16–0.63% and 1.25–2.50%, respectively). The lowest fungicidal effect was observed for Boramon (MICs and MFCs in the range of 2.5–10% and 5–20%, respectively). Devor Mousse and Pufmax preparations showed fungicidal activity at the concentrations in the range of 1.25–5%. Susceptibility profiles were also confirmed based on spot tests assay. Our study allows for unambiguously identifying isolated fungi and assessing their susceptibility to commercially available fungicides, to prevent fungal outbreak.
1. Introduction
The number of fungal species strictly belonging to Kingdom Fungi is estimated at 2.2–3.8 million, meaning that actually about 97% of the species remain undescribed [1]. Kingdom Fungi is highly diversified, and many species are able to colonize extreme environments where other organisms are unable to grow or even survive [2,3].
Such inhospitable environments can certainly include caves, which primarily due to their specific microclimate, especially low temperatures, but also lack of necessary nutrients and sun light resulting in oligotrophic conditions and are completely unattractive ecological niches to fungi [4,5,6,7]. Although light seems to be irrelevant for fungi, except about 100 species representing different taxa of fungi [8], lack of organic matter and low temperature sufficiently inhibits the spore germination and development of mycelium [9].
However, some of fungi are psychrophilic, psychrotrophic or eurythermal, allowing them to be an important part of such ecosystems [10]. For such species, low temperature is not a limiting factor, especially in a situation of high relative humidity, which in caves is always very high and most often close to 100% [11], which is also true in Niedźwiedzia Cave, where the average annual air temperature and relative humidity persist at the level of approximately 6 °C and 98% [12].
Because the cave environment is extremely oligotrophic, bats and other small vertebrates and invertebrates are important reservoirs of fungi and a source of nutrients for fungal growth after they die as recently reviewed by Nováková et al. [13]. So, it is not difficult to infer that the dead bodies of these animals become extremely attractive to them. So far, many species of fungi specializing in the colonization of skeletons and other remains of dead cave animals have been described. This issue was also reviewed recently [13].
The presence of a major or minor amount of organic matter in caves can be the result of not only its supply and accumulation by water and air movements rich in bioaerosol [14], but as it was mentioned can be associated with permanently, periodically or transiently living small vertebrates and invertebrates [14,15]. Bats [15] and Collembola [16] are considered important vectors of fungi, and bats are also a major source of organic matter [14]. Moreover, both together play an important role in spreading fungal propagules across the cave [14,15,16].
Recently, more and more attention has been paid to the role of the growing number of tourists each year, who may often be the cause of the so-called fungal outbreaks, known even from Lascaux cave [17]. Excess of visitors can not only have a negative impact on the microclimate of the cave but also these people unknowingly may spread fungal spores across the cave [15,16,17]. It is well known how fungi and other microorganisms can get into caves. Air and water are important for dispersion of fungal propagules, but any viable fungal elements can be also spread by small vertebrates (rodents, bats, etc.), invertebrates and recently more and more often by humans [18,19]. Tourists may have strong impacts on increasing fungal colonization that often results in fungal outbreaks [19,20,21]. This situation would be dangerous for both the cave environment and visitors due to the ease with which fungal propagules can randomly disperse through the cave. The most common fungi in caves belong to the genera Aspergillus, Penicillium, Mucor, Fusarium, Trichoderma and Cladosporium [5].
The vast majority of fungal species isolated from caves probably have an origin from outside environment [5,22]. However, such fungi as Acaulium caviariforme, Aspergillus baeticus, and Aspergillus thesauricus have been found only in caves or mines [5,6], and it is worth considering if they can be called troglobitic fungi. It should also be noted that the number of fungal propagules and species diversity clearly decreases during the winter, as well as moving away from the entrance deeper into the cave [23].
Fungi are capable of producing and secreting secondary metabolites that can diffuse into the rocks in caves and break down, contributing to bioweathering [24]. The presence of fungi in such environments could also have upregulating influence on cave microbiome composition and is always a challenge for preservation of museum exhibits and archaeological materials like paleolithic bones or paintings telling about the natural history of these places [20,21,25,26]. Undoubtedly, among the etiological factors of biodeterioration, microfungi pose the greatest threat to these objects [27]. Looking for the causes of biological corrosion, it is necessary to identify the causative agent. A faultless answer to this question can only be obtained agent by proceeding in accordance with Koch’s rules established in 1884 and still in force in medicine and microbiology [28].
In this work we present a complete case report describing successfully resolved problems connected with fungal colonization of cave bear (Ursus spelaeus) bones. A comprehensive approach to the situation included unambiguous species identification, based on both traditional as well as molecular techniques, and determination of susceptibility profiles of all the strains isolated toward commercially available fungicides. Results of our study allowed preventing fungal outbreak in the cave, maintaining the underground ecosystem, protecting valuable museum exhibits against biodeterioration for the future and ensuring health safety for visitors.
2. Materials and Methods
2.1. Study Area
The objects of the study, collected in January 2017, were nine bone specimens of Ursus spelaeus exhibited for tourist and located on the route for visitors in the Niedźwiedzia Cave (Kletno, Poland). Each of the suspected bones were collected aseptically using sterile gloves and placed separately into the sterile polystyrene boxes (all of them gamma sterilized). On the same day all the boxes were transferred to the laboratory for further studies. On the day of collection, the bones were damp and on the surface of some of them the growth of mycelium was visible. Full characteristics of the Niedźwiedzia Cave from which the bones were collected with data related to geographical location are given elsewhere [12,29]. Herein, it is worth mentioning that the average annual air temperature and relative humidity are on the level of approximately 6 °C and 98%, respectively [12,29]. In the context of paleolithic bones that were the subject of the study, it seems important to know that Niedźwiedzia cave is opened six days per week. Daily admission time of the cave for tourists is 8 h 30 min, which approximately translates into the total time of bones illumination. For two months, in winter, the cave is completely closed to visitors. The daily limit of visitors is 360 people on weekdays and 450 people on Saturdays and non-working days. The admissible annual number of visitors may not be higher than 87,000 people [29].
2.2. Chemicals
Among commercially available antifungal preparations taken under consideration were Boramon concentrate (Altax, Poland), Devor Mousse (Peintures et chimies, France) and Pufmax (Cherub Laboratorium, Poland). All of the antifungal chemicals have been approved for use in European Union countries [30,31,32]. Moreover, all of them as declared by the producers are strong fungicidal preparations and are recommended to fight molds, and white, and brown rot fungi, causing biodeterioration of various technical materials. The first two contain benzalkonium (C8-C16) chloride (C22H42ClNO, Mw = 372.02 g∙mol−1), which is a representant of quaternary ammonium salts in concentrations of 33% and 5%, respectively [30,31]. Additionally, the second one is enriched with the fungicide, 2-Octyl-2H-isothiazol-3-one (C11H19NOS, Mw = 213.34 g∙mol−1) at a final concentration of 2.5% [30]. Pufmax contains sodium hypochlorite (NaClO, Mw = 74.44 g∙mol−1) at final concentration 4.8%. In the product safety data sheet, it is well-established that the active component is completely biodegradable and recommended as a fungicide, which additionally removes dark stains (such as related with mycotoxins activity) from some technical materials [32]. Stock solutions for susceptibility testing were prepared by mixing original preparations with nanopure water in ratios: 1:9, 1:0 and 1:0, respectively. All the concentrations of tested preparations within this work are considered and expressed as a percentage concentrations (w/v, weight to volume ratio) or as concentrations by weight (µg∙mL−1) of biologically active compound. All chemicals used in the experiments were, if not stated otherwise, purchased from Sigma-Aldrich (Poland) and were of analytical grade.
2.3. Visual Inspection with Direct Microscopical Examination
The bones were visually inspected immediately after delivery to the laboratory. Collected bones both with and without visible traces of biodeterioration were placed in new sterile, non-pyrogenic, polystyrene boxes covered by parafilm. At the bottom of the box were sterile gauze pads moistened by sterile nanopure water, to obtain the conditions very similar to the slide culture technique incubation [33]. The boxes with bones were incubated in the dark two weeks at temperature set up at 20 ± 1 °C. Direct microscopic examination of bone scrapings was performed to show the presence of mycelial elements inside of dead bone tissue. Bone scrapings were rubbed using both sterile surgical scalpel and drill to obtain samples from deeper layers of bone. It should be mentioned that after taking swabs to set up cultures, each time before bone scrapings were rubbed using both sterile surgical scalpel and drill the bone surface was wiped with 70% ethanol to avoid any contaminations from surface. Microscopic preparations for direct examinations were prepared in dimethyl sulphoxide (DMSO) with 10% KOH, both from POCH (Gliwice, Poland) as clearing fluid [34].
2.4. Culture Conditions
For culture media inoculations the biological material containing fungal propagules was rubbed from bone surfaces using sterile cotton swabs. From each of the ten places on bone (both from parts with and without visible growth of molds) samples were taken. For each bone sample plating was made in three independent replications. Streak plate technique and serial dilution isolation method [28,35] were used for isolation into pure culture. For primary isolation three rich media were inoculated: BHI (brain heart infusion agar, Merck KGaA, Darmstadt, Germany), YPD (yeast extract peptone dextrose agar, Sigma, Saint Louis, MO, USA) and SDA (Sabouraud 4% dextrose agar, Merck KGaA, Germany) supplemented with chloramphenicol (50 µg∙mL−1) and gentamicin (100 µg∙mL−1) were used to provide the opportunity to isolate all cultivable fungi. The plates were incubated aerobically at 10, 20 and 30 ± 1 °C for 7 up to 28 days to provide breeding conditions and for cultivation slowly-growing psychrophilic and/or psychrotrophic fungi. Colonies that appeared on the media were sub-cultured on PDA (potato dextrose agar, Biocorp, Warszawa, Poland) and SDA media, then isolates were purified by the single spore technique [36]. In case of all the strains for which the optimal growth rate was observed at 10 ± 1 °C, the ability to grow at 5 ± 1 °C was also assessed (using all the mentioned above culture media). Such proceedings were particularly important given that the average temperature in the Niedźwiedzia Cave is around 6 °C [12]. To evaluate the macro- and micromorphology of the fungus cultured in greater detail, slide cultures [33] were performed on PDA, Czapek-Dox agar (Biocorp, Warszawa, Poland), CYA (Czapek yeast autolysate agar: 30.0 µg∙L−1 sucrose, 15 µg∙L−1 agar, 5.0 µg∙L−1 yeast extract, 3.0 µg∙L−1 NaNO3, 1.0 µg∙L−1 K2HPO4, 0.5 µg∙L−1 KCl, 0.5 µg∙L−1 MgSO4·7H2O, 0.01 µg∙L−1 FeSO4 7H2O) and MEA (malt extract agar, Biocorp, Warszawa, Poland) were examined after 7–21 days of incubation at 20 ± 1 °C. The fungal strains were identified based on relevant taxonomic literature focused on particular genera [37,38,39,40,41,42,43,44,45,46,47,48]. Slides were dyed with LPCB (lactophenol cotton blue, Sigma, Saint Louis, MO, USA). Photomicrographs were taken with Axio Image.M1 (Zeiss, Göttingen, Germany) and the macroscopic ones with a Nikon Coolpix.
2.5. In Vitro Susceptibility Testing
Susceptibility testing of fungal strains isolated from Ursus spelaeus bones toward commercially available antifungal preparations (Pufmax, Boramon and Devor Mousse) was performed based on CLSI (Clinical & Laboratory Standards Institute) reference method, microdilution assay (protocol M38-A2) [49] with slight modifications. Additionally, for comparison, a second protocol for susceptibility testing using the compound serial dilution technique [49] was included. Both protocols were carried out at 20 ± 1 °C instead of 35 °C, as recommended in the original protocols [49,50] since some of the isolates are psychrophilic with optimal growth temperature between 15–20 °C. Concentrated solutions of fungicides (stock solutions) were 5-fold diluted with standard liquid RPMI 1640 medium (Roswell Park Memorial Institute, containing L-glutamine, 2% glucose, without sodium bicarbonate, Sigma, Saint Louis, MO, USA) buffered using 0.165 M MOPS (morpholinepropanesulfonic acid, Sigma, Saint Louis, MO, USA) to obtain the final pH 7.0. The concentrations of the solutions prepared in this manner were two times higher than required for the test.
The inoculum suspensions in case of all the filamentous fungi were prepared in sterile RPMI 1640 medium or in saline solution (0.85% NaCl), accordingly to the protocol [49,50], respectively. All the tested strains were subcultured on PDA and incubated at temperature set up at 20 ± 1 °C) until mature colonies were obtained. For this reason, inocula of each strain were prepared from 3- to 14-day-old cultures grown on PDA. Colonies of the tested strains were covered with 10 mL of sterile 0.85% NaCl with Tween 80 to prevent conidia aggregation at final concentration of 0.025%. Each suspension was prepared by gently swabbing the surface with the sterile swab wetted in saline. Finally, the mixture of conidia and hyphal fragments was transferred to a new sterile tube. This mixture was shaken for 20 s and then kept for 15 to 20 min for sedimentation of heavy hyphal fragments, and the upper homogeneous suspensions were collected. Each time, inoculum suspensions were adjusted spectrophotometrically to optical density OD600 nm equal to ~0.125. Prepared in this way inoculum suspension was ready to use in the compound serial dilution technique. In the microdilution assay, to obtain final proper inoculum, suspensions ranged from 0.5 × 104 to 4.5 × 104 CFU·mL−1 according to CLSI protocol and such homogenous suspensions containing mostly conidia were diluted 1:50 using RPMI 1640 medium. Each time, inoculum size was confirmed by colony counts after plating (100 µL) on PDA medium from serial dilutions of the inoculum suspensions. Standardization of inoculum suspensions was also performed based on conidia or spores depending on species, counted in haemocytometer chamber. Standardized inoculum suspensions of several strains were added in a volume of 100 μL to each microwell of 96-well microtiter plate. All the plates were incubated aerobically at temperature set up at ~20 ± 1 °C with horizontal shaking (200 rpm). For quality control, each time a reference strain Aspergillus fumigatus ATCC MYA-3626 was checked for susceptibility toward amphotericin B (Sigma-Aldrich, Poznań, Poland). Each time when the MIC (minimal inhibitory concentration) value for this drug (1 µg∙mL−1) was achieved, the performed experiment was valid.
In the case of the second protocol which was used in this study, the susceptibility tests were performed in SD (synthetic dextrose) medium (0.67% yeast nitrogen base w/o amino acids, 2% dextrose), instead of RPMI1640 medium, according to the subject literature [50]. The appropriate volume of tested antifungal preparation was added to 25 mL of the dissolved and cooled SD medium. The whole volume was mixed and poured into a 90 mm diameter Petri dish. Onto the surface of plates with SD medium supplemented with antifungal preparations 5 μL of prepared inoculum suspension (as described above) was centrally spotted. Inoculated plates were incubated aerobically at temperature set up at 20 ± 1 °C).
The final concentrations of antifungal preparations tested by broth microdilution bioassay were in the range of 0.02–25% of the concentration of working solution. For susceptibility tests performed based on spot tests, SD plates were prepared with final concentrations of tested antifungal preparations in the range of 0.05–5% of the concentration of working solution.
In the microdilution assay, MIC value was defined as the lowest concentration of antifungal preparation that completely inhibited the fungal growth. MIC values were always determined relative to negative control (sterile RPMI1640 medium) and were ≤ 0.0, calculated based on optical density (OD) measurements at 600 nm in the Asys UVM 340 (Biochrom Ltd., Cambridge, UK) microplate reader. It was also checked visually. The MFC (minimal fungicidal concentration) values were determined as described elsewhere [51] with some modifications described earlier [52]. Both the MICs and MFCs were read after 72-h of incubation at 20 ± 1 °C. All susceptibility tests were performed in triplicate. Only if two replications showed identical results was the fungal strain given the final MIC/MFC value of the antifungal preparation tested. MIC values from spot tests were determined as the lowest concentration of antifungal preparation which completely inhibited growth, and this was evaluated visually. Growth inhibition percentage was calculated based on colony diameter measurements for those present on SD medium with tested concentration of fungicide and on plates free of antifungals (positive control). According to this protocol [50], only the MIC value could be determined.
2.6. Molecular Identification
To confirm classical (phenotypic) species identification, molecular speciation was performed. This involved genomic DNA extraction from fresh 3–10-day-old specimens (depending on fungal species), according to CTAB (cetyl trimethylammonium bromide) method [53] and PCR product sequencing of rDNA gene cluster obtained with ITS1/4 pair of primers. The concentration and purity of isolated genomic DNA was measured on a UV–VIS microspectrophotometer (NanoPhotometer®NP80, Implen GmbH, München, Germany). Amplification of DNA was performed in a 50 μL reaction mixture using the 2-fold concentrated PCR mixture containing a Taq polymerase (0.1 U∙μL−1), dNTP mix (0.5 mM of each), MgCl2 (4 mM) (A&A Biotechnology, Poland), 0.25 μM of each primer, ITS1: 5`-TCCGTAGGTGAACCTGCGG-3` and ITS4: 5`-TCCTCCGCTTATTGATATGC-3` (Genomed, Poland), described elsewhere [54] and 100 ng of genomic DNA as template. Amplification was performed in the BIO-RAD T100™ thermal cycler (Bio-Rad, Berkeley, CA, USA) for 35 cycles. After initial denaturation for 5 min at 94 °C, each cycle comprised 30 s denaturation at 94 °C, 30 s annealing at 55 °C, 45 s extension at 72 °C with a final extension for 7 min at 72 °C at the end of 35 cycles. Obtained PCR products were separated on agarose gel (2%), visualized by UV light using automated gel imaging instrument, the Gel Doc EZ System (BIO-RAD), purified from gel using Gel-Out Concentrator kit (A&A Biotechnology, Gdańsk, Poland), diluted to concentration equal to 50 ng∙µL−1 and sequenced by the Sequencing Service at Macrogen (The Netherlands, http://dna.macrogen.com/eng/).
2.7. Data Analyses
The PCR products sequences were analyzed using BioEdit Sequence Alignment Editor (http://www.mbio.ncsu.edu/bioedit/bioedit.html) and they were compared with those deposited in the GenBank of the National Center for Biotechnology Information (NCBI, Bethesda, city, MD, USA) using the BLAST algorithm (http://www.ncbi.nlm.nih.gov/).
The data were subjected to statistical analysis using the Statistica 13.3 package (StatSoft Polska Sp. z o.o., Kraków, Poland). For this purpose, we used one-way analysis of variance (ANOVA) and the Tukey HSD (honest significant difference) test at α ≤ 0.05. Prior to ANOVA, the percentage data were transformed to Bliss [55] angular degrees by applying the formula y = arcsin (value%) − 0.5. After transformation, the variance was approximately constant, allowing ANOVA to compare particular components [55]. Additionally, the results of susceptibility tests were presented as the mean ± SD from of at least three independent experiments (three replicates).
3. Results
Visual inspection with direct microscopical examination of bones allowed us to show that many exhibits bore visible traces of biodeterioration (cavities and crumbling bone fragments). After incubation of the bones under temperature set up at 20 ± 1 °C mycelium was visible on all samples even to the naked eye (Figure 1). Direct examination of the bone scrapings (collected using surgical scalpel) treated with dimethyl sulphoxide (DMSO) with 10% KOH showed the abundance of hyaline hyphae and lack of dark hyphae. Among observed mycelial elements regularly both septate hyphae as coenocytic hyphae were present. Many of them were wide (2–3 µm) and of irregular shape. The observed micromorphology of hyphae resembled non-dermatophyte species (Figure 2). As was expected, direct examination of the powdered bones (prepared using drill) did not show any fragments of hyphae (data not shown).

Figure 1.
Macroscopically visible active growth of micromycetes on the surface of the bones of Ursus spelaeus exhibited in the Niedźwiedzia Cave, Kletno, Poland. All the photos taken after two weeks incubation of bones at 20 ± 1 °C under laboratory conditions (specified in Section 2).

Figure 2.
Direct microscopic examination (in 10% KOH + DMSO) of powdered bone scrapings (collected using a surgical scalpel) affected by fungi. Scale bars 10 μm.
We isolated a total of 11 fungal species from the bones (Table 1). Macromorphology of colonies growing on different media (Figure 3) and micromorphology of fungal structures documented during the microscopic observations of LPCB stained preparations (Figure 4) were consistent with what we observed during the direct microscopical examination of the bone scrapings, both presence of coenocytic as regularly septated hyphae. For four of eleven isolates, coenocytic hyphae and the fastest growth rate were observed. Together with microscopic observations, this allows us to classify these fungi as Mucoromycotina. Four of eleven isolates finally identified as F. cerealis, M. aligarensis, M. alpina and C. merdarium were able to grow well at a temperature of 5 ± 1 °C (data not shown).

Table 1.
BLAST analysis of nucleotide sequences of PCR fungal products obtained in amplification reaction with ITS1 and ITS4 primers. All E values were 0.0.

Figure 3.
Macroscopic observations of 7- (A–I), 14- (K1–K4), 21- (C) and 28-day-old (K5) fungal culture, top and bottom view of a colony on various media at 25 ± 1 °C (1. Czapek yeast autolysate (CYA), 2. Czapek-Dox agar, 3. malt extract agar (MEA), 4. and 5. potato dextrose agar (PDA)) isolated from Ursus spelaeus bones in the Niedźwiedzia Cave, Poland: (A) Absidia glauca, (B) Aspergillus fumigatus, (C) Chrysosporium merdarium, (D) Fusarium cerealis, (E) Mortierella alpina, (F) Mucor aligarensis, (G) Mucor plumbeus, (H) Penicillium chrysogenum, (I) P. expansum, (J) Sarocladium strictum, (K) Scopulariopsis candida. Photos collected in column 5 show close up of surface growth of each of the eleven tested fungal strains.

Figure 4.
Microscopic observations of 21-day-old fungal culture on PDA at 25 ± 1 °C isolated from Ursus spelaeus bones in the Niedźwiedzia Cave, Poland: (A) Absidia glauca, (B) Aspergillus fumigatus, (C) Chrysosporium merdarium, (D) Fusarium cerealis, (E) Mortierella alpina, (F) Mucor aligarensis, (G) Mucor plumbeus, (H) Penicillium chrysogenum, (I) P. expansum, (J) Sarocladium strictum, (K). Scopulariopsis candida. Scale bars: A1, A2, B2, F1 = 100 μm; C2, G2, H2 = 50 μm; F2, I2, K2 = 20 μm; B1, C1, D, E, G1, H1, I1, J1, J2, K1 = 10 μm.
All the isolates which were identified based on traditional, phenotypic methods were confirmed by molecular methods. The size of obtained PCR products were in the range of 504–648 bp (Table 1). Results of molecular identification were completely consistent with those obtained by traditional methods. All the nucleotide sequences obtained with primers ITS1 and ITS4 together with the corresponding sequences to which these showed the closest match are deposited in Genbank under accession numbers in Table 1. In all of the BLAST analysis done the E values were zero (0.0) and percent of query cover and identity were in the range of 96.0–100% and 94.71–100%, respectively.
Generally, results of susceptibility tests obtained based on both methods allows us to conclude that the highest statistically significant antifungal activity was observed for Pufmax, except for MFC values (statistically similar effectiveness with Devor Mousse) and for the concentration of 1% fungicides in the spot tests method (all three tested preparations completely inhibit growth of all of eleven isolates) (Table 2 and Table 3). The MIC and MFC values determined based on microdilution assay for Pufmax were in the ranges of 0.16–0.63% and 0.63–2.50%, respectively. In turn, Devor Mousse preparation showed slightly less antifungal activity than Pufmax but significantly higher than observed for Boramon. MIC and MFC values for this compound ranged from 0.31–2.50 and 1.25–5%, respectively (Table 2). Boramon showed less antifungal activity against all fungal isolates compared with the other two preparations. MIC and MFC values were in the range of 2.5–10 and 5–20%, respectively (Table 2). It is worth noting that Devor Mousse and Pufmax preparations have a strong fungicidal effect in concentrations ranging from 1.25% to 5% and from 1.25% to 2.50%, respectively. These concentrations are much lower than those recommended by the manufacturers in commercially available preparations. Generally, the mean MIC and MFC values of Pufmax preparation in case of all fungal strains were equal to 0.47 and 2.1, respectively, and were ~2.7/1.6-fold lower than the mean MIC/MFC values of Devor Mousse and 12.1/5.63-fold lower than the mean MIC/MFC values determined based on microdilution assay for Boramon (Table 2).

Table 2.
Antifungal activity of the commercially available fungicidal preparations against a pool of fungal strains isolated from Ursus spelaeus bones in the Niedźwiedzia Cave (Poland) assessed by microdilution assay—given MIC and MFC mean values were calculated based on three independent repetitions ± standard deviation (SD).

Table 3.
Antifungal activity of the commercially available fungicidal preparations against a pool of fungal strains isolated from Ursus spelaeus bones in the Niedźwiedzia Cave (Poland) assessed by serial dilution technique (spot tests assay).
Results of susceptibility tests obtained based on spot tests method allow for observing similar tendencies as in the case of the microdilution assay method. However, there were statistically significant differences between the concentrations of the compounds, with the exception Pufmax (statistically similar effectiveness at 0.5% and 1% concentrations). This fungicide completely inhibited growth of all of eleven isolates at a concentration of 0.5%. The same effect was achieved for the other two compounds at a 2-fold higher concentration (Table 3). Similarly, it was observed in susceptibility tests performed based on microdilution assay that Devor Mousse preparation showed higher activity than Boramon (Table 3).
Overall, results of susceptibility tests obtained based on both methods show trends regarding the effectiveness of the tested fungicides against individual fungal species. Namely, all three tested preparations showed the highest activity against C. merdarium and the lowest against the strains such as M. plumbeus, M. aligarensis, M. alpina and A. glauca (Table 2 and Table 3). However, it should be emphasized that in many cases in statistical terms these fungi with other species formed groups that did not differ statistically. This is illustrated by the detailed statistical analysis presented in Table 2 and Table 3.
4. Discussion
Often valuable museum exhibits can be on display in caves related to their natural history or history of the cave’s discovery. These types of objects are particularly vulnerable if they come into the contact with soil or dust, which usually contain organic matter and are the source of microbial contamination for them [56]. A similar type of threat occurred in the case of prehistoric bones of Ursus spelaeus, which, in contact with soil and/or bat droppings, have been colonized by microfungi. Due to the wide range of different types of metabolites, including enzymes, organic acids and mycotoxins with destructive activity in relation to various types of materials, these organisms are considered the main factors of biodeterioration [57,58]. This phenomenon is manifested by the loss of the original properties of the material as a result of colonization by microorganisms, and, depending on the conditions and species spectrum, it can occur at different rates [59,60]. Practically, any material of natural origin can be the subject of microbiological corrosion, including that caused by fungi. Microfungi may even be etiological factors of bone biodeterioration, and to date, species capable of damaging their structure by secreting a rich spectrum of metabolites, including organic acids, have been described [13,61,62]. Fungi of the genus Penicillium, Aspergillus, Cladosporium, Alternaria, Aureobasidium, Ulocladium and Phoma, secrete into the colonized medium significant amounts of organic acids: citric, fumaric, oxalic and 2-ketogluconic [63,64]. These acids can lead to growth solubility of some bone components due to the formation of chelate compounds with metal cations: especially calcium, which is present in bones in the form of hydroxyapatites and calcium carbonate [62,65].
During our study of mold-colonized bones, eleven different species of fungi were isolated, among which were included: A. glauca, M. aligarensis, M. plumbeus, M. alpina, A. fumigatus, C. merdarium, F. cerealis, P. chrysogenum, P. expansum, S. strictum, and S. candida. The first four mentioned species belong to the subkingdom Mucoromycotina while the others are representants of Pezizomycotina among the subkingdom Dicarya [66]. Long-term studies performed by Alena Nováková et al. in 80 European caves and mines also showed on the surface of bones or other remains of dead animals living in such underground niches the presence of: C. merdarium, P. chrysogenum, M. plumbeus, Mortierella spp., Fusarium spp., and many species of the genera Aspergillus and Penicillium. Based on her experiences and literature reviews, she concluded that C. merdarium is the most frequently reported species from dead bats [13]. It should be underlined that many of the strains we isolated are able to produce metabolites, especially from the genus Penicillium and Aspergillus [63,67], which pose a real threat to the entire bone collection of various Pleistocene animals exhibited in the Niedźwiedzia Cave. Many of the isolated species of fungi grow actively under average annual temperatures prevailing in the cave, approximately 6 °C [12], and appear to be particularly dangerous biodeterioration factors. Based on our experiments, four of eleven isolates, M. alpina, M. aligarensis, F. cerealis and C. merdarium are psychrophilic or psychrotolerant, which is confirmed by the literature on the subject [68,69]. Pleistocene bones in themselves have no longer sufficient nutrient value for any microorganisms. Notwithstanding, under specific conditions like high humidity and presence of even trace amounts of organic matter on their surface (resulting from contamination), they can be colonized by fungi [70,71]. Fungal structures such as hyphae, fruit bodies, and spores are regularly found in archaeological bones [72]. In the case of the bones we examined, a lot of fragments of hyphae were visible in a direct examination only in the material scraped with a scalpel from the outer layers of the bone. The deeper material taken with a drill appeared to be free of fungal structures. This allows us to conclude about the shallow location of the mycelium and the actual scale of the threat from colonizing fungi.
In light of the facts described, bearing in mind not only the problem of biodeterioration of bones and other museum exhibits, but also the possible negative impact of these fungi on human and animal health, it was necessary to take effective measures to prevent fungal outbreak. It should be underlined that some of isolated strains of fungi are well known human pathogens like A. fumigatus [73], A. glauca [74] and S. candida [75]. In addition, molds, especially of the genus Aspergillus, Fusarium and Penicillium, can produce toxic compounds for humans and animals called mycotoxins, and their synthesis depends on the strain and biotic/abiotic conditions [76].
Species identification of cultivable organisms colonizing different technical materials, including museum exhibits based on both classical microbiological methods as well as molecular techniques, is crucial for choosing the proper methods of disinfection [27,28,77]. The type of material to which biocide will be applied is also important (e.g., structure, porosity and physicochemical properties) [27,77,78]. Moreover, equally important is to evaluate the susceptibility of isolated fungi toward commercially available fungicides to choose the best way of disinfection. How important it is, was the best demonstrated by the history associated with Lascaux cave [17]. Our research also confirms this.
While the Devor Mousse (5% concentration) preparation used here completely eradicated Fusarium solani, it turned out to be ineffective against black fungi of the genus Ochroconis and Exophiala [17]. In the pool of eleven fungal isolates, there was no representative of black fungi, which argued for the use of Devor Mousse, especially since this preparation showed the higher activity (lower MIC and MFC values) toward all isolates than observed for Boramon. Moreover, Devor Mousse contains not only a biologically active compound from the group of quaternary alkylammonium salts, but additionally fungicide, 2-octyl-2H-isothiazol-3-one [30]. Actually, the most numerous groups of compounds used as chemical inhibitors of biocorrosion are nitrogen compounds, including aliphatic amines such as N- (3-aminopropyl) -N-dodecylpropane 1,3-diamine and quaternary alkylammonium salts such as chloride didecyldimethylammonium [79]. Based on the literature [80,81] it is well-known that biocidal preparations containing quaternary alkylammonium salts or the newest quaternary ammonium surfactants [81], as active substances, are effective in limiting fungal population and cause no damage or physical changes on disinfected surfaces. Adsorption of these compounds on inanimate surfaces cause removal of water molecules and forming a monomolecular protective salt layer of alkylammonium, which protects the material against corrosion in the future. Quaternary alkylammonium salts are not reactive, which is why they adsorb on surfaces and do not induce any chemical reactions [80,81]. Considering the above, it was strongly recommended to use preparation from this group in the studied cave. The manufacturer of Pufmax declares a killing effect after only 15 min when using a working solution with a commercial concentration [32]. In turn, the same biocidal effect on different species of fungi in the case of Boramon preparation with working concentration (3.3%) is achieved after 6 h of exposure to this disinfectant [31]. It should be emphasized that Pufmax, although the most effective, has some side effects. Among the negative features of this product is the irritating smell from chlorine compounds (hypochlorite). In addition, the preparation is highly toxic to the environment, so it has to be prevented from release into the soil or water. In addition, just as important, due to the whitening properties of the preparation, its potential effect on the natural color and surface structure of bones should be considered [32].
According to Professor Fausta Gallo [82] from Central Institute for Book Pathology (Roma, Italy), to prevent the development of organisms responsible for the biodeterioration process it is necessary first of all to ensure appropriate environmental conditions to preserve different museum exhibits [83,84]. In this context, among the most important physical parameters are temperature and humidity [83,84], but these due to the specific microclimate in the cave cannot be stabilized and even this solution is not allowed because it can cause irreversible changes [85]. Moreover, it was described elsewhere that visitation can degrade the cave environment not only by introducing microbial propagules, which can be the source of contamination of bones, but also by raising temperature [21]. For this reason, to avoid similar problems in the future we proposed placing the bones in special sterile glass showcases, where it will be possible to maintain constant temperature and relative humidity parameters.
5. Conclusions
In summary, our studies allowed us to identify fungal species isolated from the bones of Ursus spelaeus and determine susceptibility profiles to three commercially available fungicide preparations. Based on the subject literature and results of susceptibility assay, it was possible to choose the optimal solution, i.e., recommended disinfection of bone surfaces with the use of Devor Mousse due to its high fungicidal activity confirmed in our study. The choice of this particular preparation is also argued by the possibility of excluding any negative impact on the bone surface structure, which could not be avoided by using Pufmax. We recommend carrying out the disinfection process three times, with intervals of several days between individual treatments, which will ensure that even the most resistant mycelium structures, such as spores, conidia, chlamydospores or arthrospores, have been eliminated. In order to avoid a similar problem in the future, it was also recommended that each new exhibit (bone) should pass microbiological tests and if necessary should be subjected to surface disinfection to exclude the presence of any microbial flora that could become a source of contamination for other exhibits. As it was mentioned, the soil and any organic debris including bat droppings present or applied with water to the interior of the cave constitute the main reservoir of fungi. Taking this into account, the possibility of bones’ contact with the ground should be eliminated. For this reason, it would be ideal to expose skeletons or individual bone elements in closed display cases. Finally, our recommendations allowed us to resolve a pressing problem and effectively secure priceless museum objects for the future.
Author Contributions
M.D., conceptualization, data curation, formal analysis, investigation, methodology, validation, visualization, supervision, writing – original draft; R.O., data curation, investigation, methodology, supervision, visualization; A.S., investigation. All the authors revised the paper and approved the final version.
Funding
This research did not receive any external funding.
Acknowledgments
The authors kindly thank Mateusz Kędzior (Duke University) for his help with English correction.
Conflicts of Interest
The authors declare no conflict of interest.
References
- Hawksworth, D.; Lücking, R. Fungal Diversity Revisited: 2.2 to 3.8 Million Species. Microbiol. Spectr. 2017, 5. [Google Scholar] [CrossRef]
- Gostinčar, C.; Grube, M.; De Hoog, S.; Zalar, P.; Gunde-Cimerman, N. Extremotolerance in fungi: Evolution on the edge. FEMS Microbiol. Ecol. 2010, 71, 2–11. [Google Scholar] [CrossRef] [PubMed]
- Zhang, X.; Li, S.J.; Li, J.J.; Liang, Z.Z.; Zhao, C.Q. Novel Natural Products from Extremophilic Fungi. Mar. Drugs 2018, 16, 194. [Google Scholar] [CrossRef] [PubMed]
- Adetutu, E.M.; Ball, A.S. Microbial diversity and activity in caves. Microbiol. Aust. 2014, 35, 192–194. [Google Scholar] [CrossRef]
- Vanderwolf, K.J.; Malloch, D.; McAlpine, D.F.; Forbes, G.J. A world review of fungi, yeasts, and slime molds in caves. Int. J. Speleol. 2013, 42, 77–96. [Google Scholar] [CrossRef]
- Zhang, Z.F.; Zhao, P.; Cai, L. Origin of cave fungi. Front. Microbiol. 2018, 9, 1407. [Google Scholar] [CrossRef]
- Candiroglu, B.; Dogruoz-Gungor, N. Cave Ecosystems: Microbiological View. Eur. J. Biol. 2017, 76, 36–42. [Google Scholar] [CrossRef]
- Bahn, Y.S.; Xue, C.; Idnurm, A.; Rutherford, J.C.; Heitman, J.; Cardenas, M.E. Sensing the environment: Lessons from fungi. Nat. Rev. Microbiol. 2007, 5, 57–69. [Google Scholar] [CrossRef]
- Sephton-Clark, P.C.S.; Voelz, K. Spore Germination of Pathogenic Filamentous Fungi. Adv. Appl. Microbiol. 2018, 102, 117–157. [Google Scholar]
- Hassan, N.; Rafiq, M.; Hayat, M.; Shah, A.A.; Hasan, F. Psychrophilic and psychrotrophic fungi: A comprehensive review. Rev. Environ. Sci. Biotechnol. 2016, 15, 147–172. [Google Scholar] [CrossRef]
- Lunghi, E.; Manenti, R.; Ficetola, G.F. Cave features, seasonality and subterranean distribution of non-obligate cave dwellers. PeerJ 2017, 5, e3169. [Google Scholar] [CrossRef] [PubMed]
- Ogórek, R.; Lejman, A.; Matkowski, K. Fungi isolated from Niedźwiedzia Cave in Kletno (Lower Silesia, Poland). Int. J. Speleol. 2013, 42, 161–166. [Google Scholar] [CrossRef]
- Nováková, A.; Kubátová, A.; Sklenář, F.; Hubka, V. Microscopic fungi on cadavers and skeletons from cave and mine environments. Czech Mycol. 2018, 70, 101–121. [Google Scholar]
- Borda, D.R.; Năstase-Bucur, R.M.; Spȋnu, M.; Uricariu, R.; Mulec, J. Aerosolized microbes from organic rich materials: Case study of bat guano from caves in Romania. J. Cave Karst Stud. 2014, 76, 114–126. [Google Scholar] [CrossRef]
- Alfaro, A. Psychrophilic and psychrotolerant fungi on bats and the presence of Geomyces spp. on bat wings prior to the arrival of white nose syndrome. Appl. Environ. Microb. 2013, 79, 54–65. [Google Scholar]
- Oliveira, M.P.A.; Bernardi, L.F.O.; Zeppelini, D.; Ferreira, R.L. First report of cave springtail (Collembola, Paronellidae) parasitized by mite (Parasitengona, Microtrombidiidae). Subterr. Biol. 2016, 17, 133–139. [Google Scholar] [CrossRef]
- Martin-Sanchez, P.; Novaákovaá, A.; Bastian, F.; Alabouvette, C.; Saiz-Jimenez, C. Use of biocides for the control of fungal outbreaks in subterranean environments: The case of the Lascaux Cave in France. Environ. Sci. Technol. 2012, 46, 3762–3770. [Google Scholar] [CrossRef]
- Bastian, F.; Alabouvette, C.; Saiz-Jimenez, C. The impact of arthropods on fungal community structure in Lascaux Cave. J. Appl. Microbiol. 2009, 106, 1456–1462. [Google Scholar] [CrossRef]
- Shapiro, J.; Pringle, A. Anthropogenic influences on the diversity of fungi isolated from caves in Kentucky and Tennessee. Am. Midl. Nat. 2010, 163, 76–86. [Google Scholar] [CrossRef]
- Bastian, F.; Jurado, V.; Nováková, A.; Alabouvette, C.; Saiz-Jimenez, C. The microbiology of Lascaux Cave. Microbiology 2010, 156, 644–652. [Google Scholar] [CrossRef]
- Griffin, D.W.; Gray, M.A.; Lyles, M.B.; Northup, D.E. The Transport of Nonindigenous Microorganisms into Caves by Human Visitation: A Case Study at Carlsbad Caverns National Park. Geomicrobiol. J. 2014, 31, 175–185. [Google Scholar]
- Zhang, Z.F.; Liu, F.; Zhou, X.; Liu, X.Z.; Liu, S.J.; Cai, L. Cultivable mycobiota from Karst caves in China, with descriptions of 20 new species. Persoonia 2017, 39, 1–31. [Google Scholar] [CrossRef] [PubMed]
- Pusz, W.; Król, M.; Zwijacz-Kozica, T. Airborne fungi as indicators of ecosystem disturbance: An example from selected Tatra Mountains caves (Poland). Aerobiologia 2018, 34, 111–118. [Google Scholar] [CrossRef] [PubMed]
- Burford, E.P.; Fomina, M.; Gadd, G.M. Fungal involvement in bioweathering and biotransformation of rocks and minerals. Miner. Mag. 2003, 67, 1127–1155. [Google Scholar]
- Dupont, J.; Jacquet, C.; Dennetiere, B.; Lacoste, S.; Bousta, F.; Orial, G.; Cruaud, C.; Couloux, A.; Roquebert, M.F. Invasion of the French Paleolithic painted cave of Lascaux by members of the Fusarium solani species complex. Mycologia 2007, 99, 526–533. [Google Scholar] [CrossRef]
- Jurado, V.; Sanchez-Moral, S.; Saiz-Jimenez, C. Entomogenous fungi and the conservation of the cultural heritage: A review. Int. Biodeterior. Biodegrad. 2008, 62, 325–330. [Google Scholar]
- Sterflinger, K.; Piñar, G. Microbial deterioration of cultural heritage and works of art—Tilting at windmills? Appl. Microbiol. Biotechnol. 2013, 97, 9637–9646. [Google Scholar] [CrossRef]
- Salyers, A.A.; Whitt, D.D.; Wessner, D.; Elmendorf, H.; Stephens, C.M. Microbiology: Diversity, Disease, and the Environment, 2nd ed.; Fitzgerald Science Press, Inc.: Bethesda, MD, USA, 2001; pp. 297–298. [Google Scholar]
- Official Website of Niedźwiedzia Cave. Available online: http://jaskinianiedzwiedzia.pl/ (accessed on 21 October 2019). (In Polish).
- Devor Mousse (Product Specification Sheet). Available online: http://oxi-peintures.com/media/ft_antimousse_concentre_devor_mousse__034946500_1601_20082013 (accessed on 21 October 2019).
- Altax (Product Specification Sheet). Available online: http://www.promesa-farby.pl/download/Karty%20±1oCharakterystyki%20i%20atesty/ALTAX/Karty%20±1oCharakterystyki/BORAMON%20%C2%8CRODEK%20GRZYBOB%C3%93JCZY_karta%20±1oCharakterystyki.pdf (accessed on 21 October 2019).
- Pufmax (Product Specification Sheet). Available online: http://www.cherub.com.pl/upload/impregnaty//Dokumenty//PUFMAKS-POGROMCA-PLESNI-v-3-22-05-2014.pdf (accessed on 21 October 2019).
- McGinnis, M.R. Laboratory Handbook of Medical Mycology; Academic Press, Inc.: New York, NY, USA, 1980; pp. 132–133. [Google Scholar]
- Nishimoto, K.; Takemoto, H. A simple staining and mounting method of KOH preparations for mycological examination using Parker-blue-black ink. Jpn. J. Med. Mycol. 1979, 20, 145–147. [Google Scholar] [CrossRef]
- Garrett, S.D. Soil Fungi and Soil Fertility: An Introduction to Soil Mycology, 2nd ed.; Pergamon Press: Oxford, UK, 1981; pp. 1–64. [Google Scholar]
- Choi, Y.W.; Hyde, K.D.; Ho, W.H. Single spore isolation of fungi. Fungal Divers. 1999, 3, 29–38. [Google Scholar]
- Domsch, K.H.; Gams, W.; Anderson, T.H. Compedium of Soil Fungi, 2nd ed.; IHW Verlag: Eching, Germany, 2007; pp. 1–672. [Google Scholar]
- de Hoog, G.S. Atlas of Clinical Fungi, 2nd ed.; CBS-KNAW Fungal Biodiversity Centre: Utrecht, The Netherlands, 2000; pp. 1–1126. [Google Scholar]
- Samson, R.A.; Varga, J. Aspergillus Systematics in the Genomic Era; CBS Fungal Biodiversity Centre: Utrecht, The Netherlands, 2017. [Google Scholar]
- Samson, R.A.; Varga, J.; Frisvad, J.C. Taxonomic studies on the genus Aspergillus. Stud. Mycol. 2011, 69, 1–97. [Google Scholar]
- Samson, R.A.; Houbraken, J. Phylogenetic and taxonomic studies on the genera Penicillium and Talaromyces. Stud. Mycol. 2011, 70, iii. [Google Scholar]
- Frisvad, J.C.; Samson, R.A. Polyphasic taxonomy of Penicillium subgenus Penicillium A guide to identification of food and air-borne terverticillate Penicillia and their mycotoxins. Stud. Mycol. 2004, 49, 1–174. [Google Scholar]
- Samson, R.A.; Cobus, M.; Visagie, C.M.; Houbraken, J. Species Diversity in Aspergillus, Penicillium and Talaromyces; CBS Fungal Biodiversity Centre: Utrecht, The Netherlands, 2014. [Google Scholar]
- Seifert, K.; Morgan-Jones, G.; Gams, W.; Kendrick, B. The Genera of Hyphomycetes; CBS Biodiversity Series; CBS-KNAW Fungal Biodiversity Centre: Utrecht, The Netherlands, 2011; pp. 1–997. [Google Scholar]
- Guarro, J.; Gene, J.; Stchigel, A.M.; Figueras, M.J. Atlas of Soil Ascomycetes; CBS Biodiversity Series; CBS-KNAW Fungal Biodiversity Centre: Utrecht, The Netherlands, 2012; Volume 10, pp. 1–486. [Google Scholar]
- Hubka, V.; Nováková, A.; Peterson, S.W.; Frisvad, J.; Sklenár, F.; Matsuzawa, T.; Kubátová, A.; Kolarik, M. A reappraisal of Aspergillus section Nidulantes with descriptions of two new sterigmatocystin-producing species. Plant Syst. Evol. 2016, 302, 1267–1299. [Google Scholar] [CrossRef]
- Sandoval-Denis, M.; Guarro, J.; Cano-Lira, J.F.; Sutton, D.A.; Wiederhold, N.P.; de Hoog, G.S.; Abbott, S.P.; Decock, C.; Sigler, L.; Gene, J. Phylogeny and taxonomic revision of Microascaceae with emphasis on synnematous fungi. Stud. Mycol. 2016, 83, 193–233. [Google Scholar] [CrossRef] [PubMed]
- Chen, A.J.; Frisvad, J.C.; Sun, B.D.; Varga, J.; Kocsube, S.; Dijksterhuis, J.; Kim, D.H.; Hong, S.B.; Houbraken, J.; Samson, R.A. Aspergillus section Nidulantes (formerly Emericella): Polyphasic taxonomy, chemistry and biology. Stud. Mycol. 2016, 84, 1–118. [Google Scholar] [CrossRef] [PubMed]
- Clinical and Laboratory Standards Institute. Reference Method for Broth Dilution Antifungal Susceptibility Testing of Filamentous Fungi-Approved Standard, CLSI Document M38-A2, 2nd ed.; CLSI: Wayne, PA, USA, 2008; pp. 3–30. [Google Scholar]
- Kaiser, C.; Michaelis, S.; Mitchel, A.A. Methods in Yeast Genetics; Cold Spring Harbor Laboratory Course Manual; Cold Spring Harbor Laboratory Press: New York, NY, USA, 1994; pp. 195–197. [Google Scholar]
- Espinel-Ingroff, A.; Walsh, T.J.; Fothergill, A.; Peter, J.; Rinaldi, M.G.; Walsh, T.J. Testing conditions for determination of Minimum Fungicidal Concentrations of new and established antifungal agents for Aspergillus spp. NCCLS collaborative study. J. Clin. Microbiol. 2002, 40, 3204–3208. [Google Scholar] [CrossRef]
- Dyląg, M.; Pruchnik, H.; Pruchnik, F.; Majkowska-Skrobek, G.; Ułaszewski, S. Antifungal activity of organotin compounds with functionalized carboxylates evaluated by the micro-dilution bioassay in vitro. Med. Mycol. 2010, 48, 373–383. [Google Scholar] [CrossRef]
- Zhang, Y.; Zhang, S.; Liu, X.; Wen, H.; Wang, M. A simple method of genomic DNA extraction suitable for analysis of bulk fungal strains. Lett. Appl. Microbiol. 2010, 51, 114–118. [Google Scholar] [CrossRef]
- White, T.J.; Bruns, T.; Lee, S.; Taylor, J.W. Amplification and Direct Sequencing of Fungal Ribosomal RNA Genes for Phylogenetics. In PCR Protocols: A Guide to Methods and Applications, 1st ed.; Innis, M.A., Gelfand, D.H., Sninsky, J.J., White, T.J., Eds.; Academic Press: New York, NY, USA, 1990; pp. 315–322. [Google Scholar]
- Bliss, C.T. The method of probits. Science 1934, 79, 38–39. [Google Scholar] [CrossRef]
- Ana-Maria, B.; Ion, S. Monitoring of pollutants in museum environment. PESD 2015, 9, 173–180. [Google Scholar] [CrossRef]
- Nittérus, M. Fungi in archives and libraries, a literary survey. Restaurator 2000, 21, 25–40. [Google Scholar]
- Montanari, M.; Melloni, V.; Pinzari, F.; Innocenti, G. Fungal biodeterioration of historical library materials stored in Compactus movable shelves. Int. Biodeterior. Biodegrad. 2012, 75, 83–88. [Google Scholar] [CrossRef]
- Hueck, H.J. The biodeterioration of materials—An appraisal. Int Biodeterior. Biodegrad. 2001, 48, 5–11. [Google Scholar] [CrossRef]
- Morton, L.H.G. Things that go rot in the night—A review of biodeterioration. Microbiol. Today 2003, 30, 103–106. [Google Scholar]
- Child, A.M. Microbial taphonomy of archaeological bone. Stud. Conserv. 1995, 40, 19–30. [Google Scholar]
- Jans, M.M. Microbial bioerosion of bone—A review. Current Developments in Bioerosion. In Erlangen Earth Conference Series, 2nd ed.; Wisshak, M., Tapanila, L., Eds.; Springer: Berlin, Germany, 2008; pp. 397–413. [Google Scholar]
- Gutarowska, B.; Czyżowska, A. The ability of filamentous fungi to produce acids on indoor building materials. Ann. Microbiol. 2009, 59, 807–813. [Google Scholar] [CrossRef]
- Sazanova, K.; Shchiparev, S.; Vlasov, D. Formation of organic acids by fungi isolated from the surface of stone monuments. Microbiology 2014, 83, 516–522. [Google Scholar] [CrossRef]
- Warscheid, T.; Braams, J. Biodeterioration of stone: A review. Int. Biodeterior. Biodegrad. 2000, 46, 343–368. [Google Scholar] [CrossRef]
- Tedersoo, L.; Sánchez-Ramírez, S.; Kõljalg, U. High-level classification of the Fungi and a tool for evolutionary ecological analyses. Fungal Divers. 2018, 90, 135–159. [Google Scholar] [CrossRef]
- Slack, G.J.; Puniani, E.; Frisvad, J.C.; Samson, R.A.; Miller, J.D. Secondary metabolites from Eurotium species, Aspergillus calidoustus and A. insuetus common in Canadian homes with a review of their chemistry and biological activities. Mycol. Res. 2009, 113, 480–490. [Google Scholar] [CrossRef]
- Duarte, A.; dos Santos, J.A.; Vianna, M.V.; Freitas-Vieira, J.M.; Mallagutti, V.H.; Inforsato, F.J.; Wentzel, L.C.P.; Lario, L.D.; Rodrigues, A.; Pagnocca, F.C.; et al. Cold-adapted enzymes produced by fungi from terrestrial and marine Antarctic environments. Crit. Rev. Biotechnol. 2018, 38, 600–619. [Google Scholar] [CrossRef] [PubMed]
- Chaturvedi, V.; DeFiglio, H.; Chaturvedi, S. Phenotype profiling of white-nose syndrome pathogen Pseudogymnoascus destructans and closely-related Pseudogymnoascus pannorum reveals metabolic differences underlying fungal lifestyles. F1000Research 2018, 7, e665. [Google Scholar] [CrossRef] [PubMed]
- Krishnan, A.; Alias, A.S.; Wong, C.M.V.L.; Ka-Lai Pang, K.-L.; Convey, P. Extracellular hydrolase enzyme production by soil fungi from King George Island, Antarctica. Polar Biol. 2011, 34, 1535–1542. [Google Scholar] [CrossRef]
- Riordan, F. Minimum conditions for visible mold growth. ASHRAE J. 2016, 58, 32–43. [Google Scholar]
- Jans, M.M.E.; Nielsen-Marsh, C.M.; Smith, C.I.; Collins, M.J.; Kars, H. The characterisation of microbial attack in archaeological bone. J. Archaeol. Sci. 2004, 31, 87–95. [Google Scholar] [CrossRef]
- Dagenais, T.R.T.; Keller, N.P. Pathogenesis of Aspergillus fumigatus in Invasive Aspergillosis. Clin. Microbiol. Rev. 2009, 22, 447–465. [Google Scholar] [CrossRef]
- Hoffmann, K.; Discher, S.; Voigt, K. Revision of the genus Absidia (Mucorales, Zygomycetes) based on physiological, phylogenetic, and morphological characters; thermotolerant Absidia spp. form a coherent group, Mycocladiaceae fam. nov. Mycol. Res. 2007, 111, 1169–1183. [Google Scholar] [CrossRef]
- Sandoval-Denis, M.; Sutton, D.A.; Fothergill, A.W.; Cano-Lira, J.; Gené, J.; Decock, C.A.; de Hoog, G.S.; Guarro, J. Scopulariopsis, a poorly known opportunistic fungus: Spectrum of species in clinical samples and in vitro responses to antifungal drugs. J. Clin. Microbiol. 2013, 51, 3937–3943. [Google Scholar] [CrossRef]
- Tola, M.; Kebede, B.; Yildiz, F. Occurrence, importance and control of mycotoxins: A review. Cogent Food Agric. 2016, 2, 1191103. [Google Scholar] [CrossRef]
- Block, S.S. Disinfection, Sterilization, and Preservation, 5th ed.; Lippincott Williams and Wilkins: Walnut Street, PA, USA, 2001; pp. 110–1320. [Google Scholar]
- Szczepanowska, H.M. Conservation of Cultural Heritage: Key Principles and Approaches, 1st ed.; Routledge: London, UK, 2013; pp. 12–234. [Google Scholar]
- Diaz-Herraiz, M.; Jurado, V.; Cuezva, S.; Laiz, L.; Pallecchi, P.; Tiano, P.; Sanchez-Moral, S.; Saiz-Jimenez, C. The actinobacterial colonization of Etruscan paintings. Sci. Rep. 2013, 3, 1440. [Google Scholar] [CrossRef]
- Brycki, B. Gemini alkylammonium salts as biodeterioration inhibitors. Pol. J. Microbiol. 2010, 59, 227–231. [Google Scholar] [PubMed]
- Perinelli, D.R.; Petrelli, D.; Vitali, L.A.; Vllasaliu, D.; Cespi, M.; Giorgioni, G.; Elmowafy, E.; Bonacucina, G.; Palmieri, G.F. Quaternary ammonium surfactants derived from leucine and methionine: Novel challenging surface active molecules with antimicrobial activity. J. Mol. Liq. 2019, 283, 249–256. [Google Scholar] [CrossRef]
- Gallo, F. Aerobiological research and problems in libraries. Aerobiologia 1993, 9, 117–130. [Google Scholar] [CrossRef]
- Kompatscher, K.; Kramer, R.P.; Ankersmit, B.; Schellen, H.L. Intermittent conditioning of library archives: Microclimate analysis and energy impact. Build. Environ. 2019, 147, 50–66. [Google Scholar] [CrossRef]
- de Freitas, C.R. The role and importance of cave microclimate in the sustainable use and management of show caves. Acta Carsologica 2010, 39, 477–489. [Google Scholar] [CrossRef]
- Cigna, A.A.; Forti, P. Caves: The most important geotouristic feature in the world. Tour. Karst Areas 2013, 6, 9–26. [Google Scholar]
© 2019 by the authors. Licensee MDPI, Basel, Switzerland. This article is an open access article distributed under the terms and conditions of the Creative Commons Attribution (CC BY) license (http://creativecommons.org/licenses/by/4.0/).